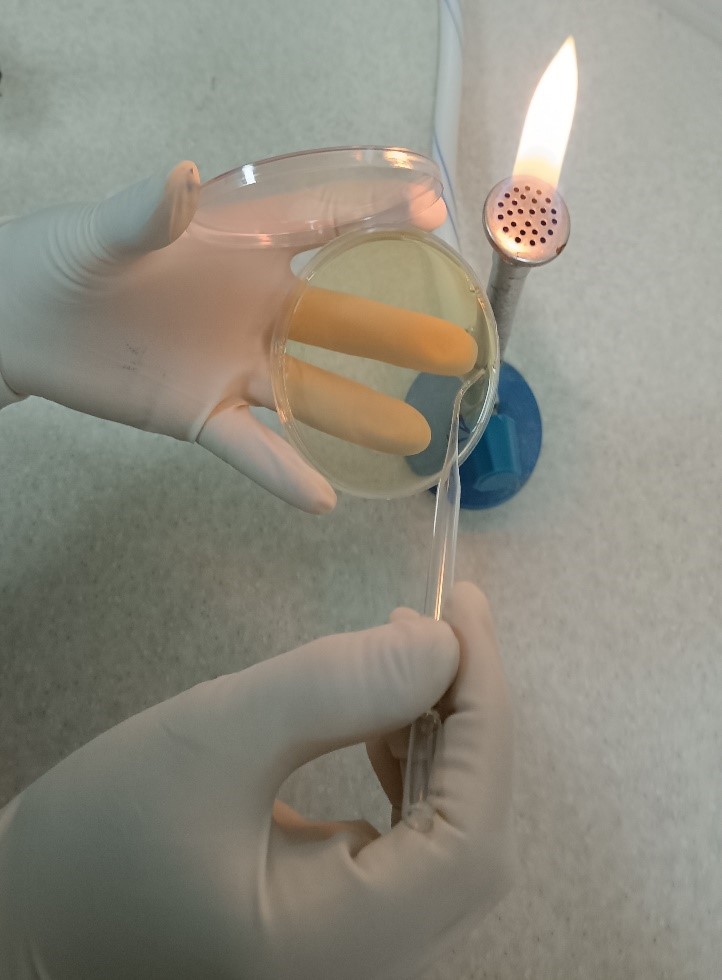
m/روش مستقیم برای آزمایش بار زیستی

روش مستقیم برای آزمایش بار زیستی
روش های مستقیم برای آزمایش بایووبردن شامل روش های Pour plate و spared می باشند.
روش Pour plate به دلیل دقت بیشتر ترجیح داده می شود. در روش پور پلیت،1 میلی لیتر از نمونه مورد آزمون یا رقت آن را در هر ظرف پتری دیش به صورت آسپتیک ریخته، به هر ظرف 15 تا 20 میلی لیتر از محیط آگار استریل شده که قبلا ذوب شده و در دمای زیر 45 درجه سانتیگراد نگهداری شده است، اضافه و مخلوط می شود .

در روش کشت سطحی یا spared، نمونه مایع مورد آزمایش روی سطح جامد و خشک محیط کشت آگار قرار داده و به طور یکنواخت پخش می شود.
در هر دو روش، پس از کشت دادن نمونه، پلیت انکوبه می شود و پس از انکوباسیون تعداد کلنی های رشد یافته در پلیت شمارش می شوند.
روش مستقیم برای آزمایش بار زیستی
روش های مستقیم برای آزمایش بایوبردن شامل روش های Pour plate و spared می باشند.
روش Pour plate به دلیل دقت بیشتر ترجیح داده می شود. در روش پور پلیت،1 میلی لیتر از نمونه مورد آزمون یا رقت آن را در هر ظرف پتری دیش به صورت آسپتیک ریخته، به هر ظرف 15 تا 20 میلی لیتر از محیط آگار استریل شده که قبلا ذوب شده و در دمای زیر 45 درجه سانتیگراد نگهداری شده است، اضافه و مخلوط می شود .
در روش کشت سطحی یا spared، نمونه مایع مورد آزمایش روی سطح جامد و خشک محیط کشت آگار قرار داده و به طور یکنواخت پخش می شود.
در هر دو روش، پس از کشت دادن نمونه، پلیت انکوبه می شود و پس از انکوباسیون تعداد کلنی های رشد یافته در پلیت شمارش می شوند.
- مقالات بیشتر:
- تست اندوتوکسین چیست
- عملکرد اندوتوکسین
- اندوتوکسین و اگزوتوکسین چیست
روش بیشترین تعداد احتمالی یا MPN (Most Probable Number) برای آزمایش بار زیستی
MPN یا روش چند لوله ای (multi-tube method) یا روش McCrady، یک روش کمی مبتنی بر آمار و احتمالات است که برای تعیین تعداد تقریبی باکتریهای زنده در یک نمونه استفاده می شود. این روش معمولا برای آن دسته از مواد که احتمال حضور میکروارگانیسم ها در آنها کم (کمتر از 10 عدد در هر گرم) است و اسفاده از روش پور پلیت کلاسیک شمارش دقیقی را حاصل نمی کند، به کار می رود. این روش معمولا برای آزمون میکروبی مواد غذایی یا آب از لحاظ وجود کلیفرمها استفاده می شود. وجود کلیفرمهای مدفوعی، یکی از مارکرهای آلودگی مدفوعی در مواد غذایی و آب محسوب می شود. تعداد بسیار کم کلیفرمها در آب نشان دهنده اینست که آب احتمالا حاوی میکروارگانیسمهای بیماری زا نیست، درحالیکه وجود تعداد زیادی از باکتریهای کلیفرم مدفوعی نشان دهنده احتمال وجود میکروارگانیسم های بیماری زا می باشد و آب مورد آزمون قابل استفاده نیست.
روش MPN شامل سه مرحله آزمون 1- فرضی، 2- تایید و 3- تکمیلی می باشد. در این روش باکتری E. coli به عنوان شاخص آلودگی آب در نظر گرفته می شود. برای انجام این آزمون آب مورد آزمایش در لاکتوز براث کشت داده می شود. در صورت وجود کلیفرمها در آب، لاکتوز موجود در محیط مصرف می شود و گاز و اسید تولید می گردد. وجود اسید با تغییر رنگ محیط مشخص می شود و وجود گاز با حضور حباب های گاز درون لوله دورهام که به طور وارونه در محیط قرار داده می شود، تشخیص داده می شود. تعداد کلی کلیفرمها و در نتیجه احتمال آلودگی مدفوعی، با شمارش تعداد لوله های واکنش مثبت (تولید گاز و تغییر رنگ) تخمین زده می شود. مرحله اول این آزمایش فرضی است زیرا گونه های مختلف باکتری دیگر می توانند نتایج یکسانی را در این شرایط به دست آورند و باعث نتایج مثبت کاذب شوند. بنابراین، آزمون اولیه نیاز به مرحله تاییدی دارد. در این مرحله می توان از محیط های کشت دیگری که به طور اختصاصی موجب رشد کلیفرم ها میشوند نظیر محیط EMB آگار و BGLB استفاده می شود. تشکیل گاز در براث لاکتوز و تشکیل کلنی کلیفرم مانند بر روی EMB آگار تایید وجود یک عضو کلیفرم را در نمونه نشان می دهد. در مرحله تکمیلی اگر ارگانیسم یک باکتری میله ای گرم منفی و غیر اسپورزا، ایندول مثبت باشد، وجود E.coli در نمونه آب تایید می شود.

برای کسب اطلاعات بیشتر و دریافت خدمات با ما تماس بگیرید.





